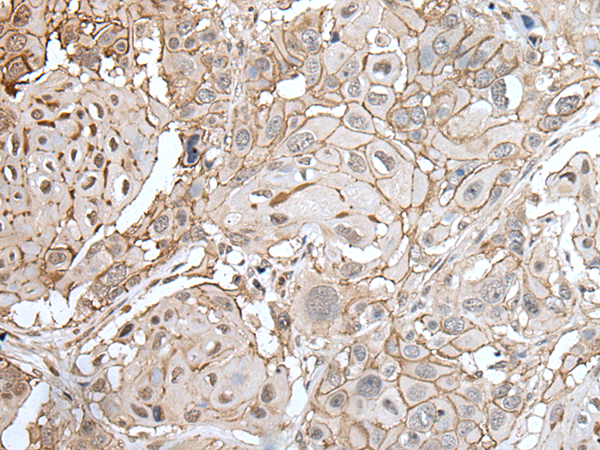

别名:应用:IHC
反应种属:Human, Mouse
规格:50μl/100μl
| Description |
|---|
| Tight junctions represent one mode of cell-to-cell adhesion in epithelial or endothelial cell sheets, forming continuous seals around cells and serving as a physical barrier to prevent solutes and water from passing freely through the paracellular space. These junctions are comprised of sets of continuous networking strands in the outwardly facing cytoplasmic leaflet, with complementary grooves in the inwardly facing extracytoplasmic leaflet. This gene encodes a component of tight junction strands, which is a member of the claudin family. The protein is an integral membrane protein and is one of the entry cofactors for hepatitis C virus. The gene methylation may be involved in esophageal tumorigenesis. This gene is adjacent to another family member CLDN9 on chromosome 16. |
| Specification | |
|---|---|
| Swissprot | P56747 |
| Host/Isotype | Rabbit IgG |
| Storage | Store at 4°C short term. Aliquot and store at -20°C long term. Avoid freeze/thaw cycles. |
| Species Reactivity | Human, Mouse |
| Immunogen | Synthetic peptide of human CLDN6 |
| Formulation | pH7.4 PBS, 0.05% NaN3, 40% Glycerol |
| Application | |
|---|---|
| IHC | 1/25-1/100 |
| ELISA | 1/5000-1/10000 |
 |
The image is immunohistochemistry of paraffin-embedded Human colorectal cancer tissue using P05630(CLDN6 Antibody) at dilution 1/25. (Original magnification: ×200) |
|
The image is immunohistochemistry of paraffin-embedded Human esophagus cancer tissue using P05630(CLDN6 Antibody) at dilution 1/25. (Original magnification: ×200) |
本公司的所有产品仅用于科学研究或者工业应用等非医疗目的,不可用于人类或动物的临床诊断或治疗,非药用,非食用。
暂无评论
本公司的所有产品仅用于科学研究或者工业应用等非医疗目的,不可用于人类或动物的临床诊断或治疗,非药用,非食用。
 中文
中文 








发表回复